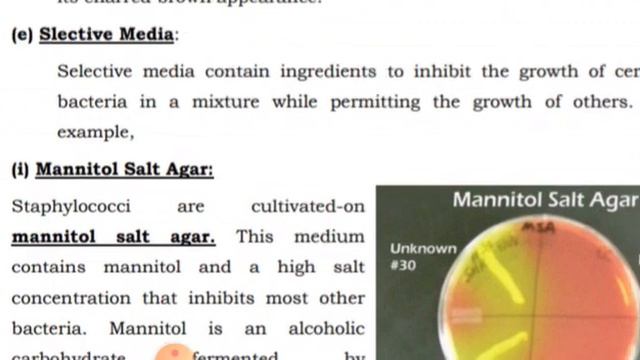
Types of culture media, Microbiology lecture by: Dr. Abdul Manaf Alvi смотреть онлайн

Автор / Канал: Звездные истории: Истории звезд Страница 5

Прохождение Hi-Fi RUSH #1

Suzanne Ciani - Andalusian Dream (from Dream Suite)

LAMBORGHINI Diablo (Short Documentary)

Kaut ko klusiņām, klusiņām

Rosana Bertone sobre los comentarios de Macri: "Me indigna como Gobernadora"

Henri camara l'ancien international

17th Sailor Today Sea Shore Awards 2018 Glimpses : Seafarer Entrepreneur of the Year

Марсик ждёт маму 😊🥰 Марфа Васильевна с нами.

Buddy last drive TD highlight Overhills

Pasha Kabab | Beef Kabab | Turkish Cuisine Recipe by Kandeel's Kitchen

Гитара.2.Батыр Усманов

Les doy el número de valentina zenere y de karol a los 50 me gusta

Шац #598 (07.07.2019)

Nokor Meredov Baharym (Turkmençe aýdym)

Women's 10m platform bronze: Pandelela Rinong

يتنكر قزم صغير بشكل رضيع 🙂من أجل سرقة الماسة بقيمة ملايين الدولارات💰|ملخص فيلم Littel Man

Bokeh Intro

Most Inspirational Motivational Story | By Engr.Amir Sultan

Nikola & David Wedding

золотко и хулиган
Types of culture media, Microbiology lecture by: Dr. Abdul Manaf Alvi

Caterina Calvi - Donizetti - Amore e Morte

"Qissasi rabğuziy" muqaddima. Xidoyat yo'lida, xikmatli so'zlar

Kendrick Perkins replies Draymond "ogre" comment
За каждым успешным каналом стоит личность, идея и сотни часов кропотливого труда. Если вы здесь, значит, автор «Звездные истории: Истории звезд» уже сумел зацепить ваше внимание своим уникальным стилем или подачей. А мы на RUVIDEO позаботились о том, чтобы вы могли изучить весь архив его работ в максимально комфортных условиях — без лишней суеты и преград.
Почему за работами канала «Звездные истории: Истории звезд» так интересно наблюдать? Всё просто: это честный контент, который находит отклик в сердцах зрителей. На нашем ресурсе вы можете смотреть онлайн все видео любимого автора бесплатно и в хорошем качестве. Нам важно, чтобы вы видели каждую деталь и слышали каждый нюанс, поэтому мы используем только стабильные плееры из открытых источников Rutube.
Следите за новинками канала, пересматривайте старые шедевры и открывайте для себя новые грани творчества «Звездные истории: Истории звезд». Мы постоянно обновляем ленту, чтобы у вас под рукой всегда были самые свежие выпуски. Никаких сложных регистраций — только вы и творчество, которое вдохновляет. Приятного вам путешествия по миру авторского контента на RUVIDEO!
Видео взято из открытых источников Rutube. Если вы правообладатель, обратитесь к первоисточнику.